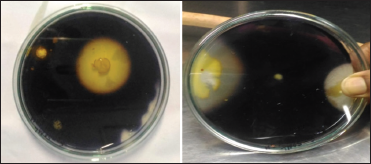
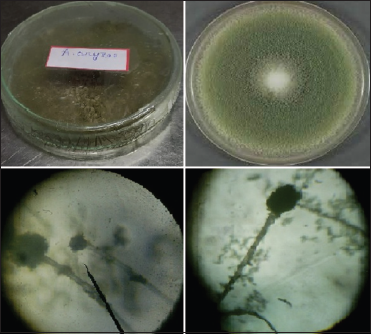

1. INTRODUCTION
Alpha-amylase (E.C.3.2.1.1) is one of the most essential bio technologically industrial enzymes, having numerous applications in a wide range of industries [1]. Its manufacturing now accounts for up to 65% of the global enzyme market and is steadily expanding [2]. Kuhn named it in 1925 because the hydrolysis products are in the alpha configuration [3]. It disintegrates starch by hydrolyzing its terminal-1,4-glycosidic bond, generating maltose or maltose, glucose, and limit dextrin from amylopectin [4]. They are often divided into two parts; saccharifying α-amylase hydrolyzes 50–60% whereas liquefying α-amylase hydrolyzes 30–40% [5]. Alpha-amylase is synthesized by a diverse variety of living creatures, including bacteria, plants, and mammals. Many bacteria such as Bacillus sp., Lactobacillus sp., Pseudomonas sp., and Fungi like Aspergillus sp. are the sources of this enzyme [6]. Vegetables such as cauliflower and onion also contain a small amount of alpha-amylase, and in the human body, it is obtained from salivary gland and pancreas [7].
The specific activity of alpha-amylase is depended on various biochemical phenotype parameters such as substrate, pH, and temperature as well as metal ions requirements [8]. In general, starch is used as a substrate for the enzyme assay because it degrades starch by hydrolysis of a terminal α-1,4-glycosidic bond to reduce maltose, glucose and limit dextrin. Optimum pH of human salivary and pancreatic α-amylases is neutral. Still, earlier studies show that pH may vary from species to species and showed their optimum pH in a range of 4–10 [7]. The impact of temperature on the production of amylases is related to the emergence of organisms [9]. Metal ions are acts as a co-factor, but their binding capacity may increase or decrease the enzyme activity [10]. In general, from various studies, it was found that metal ions such as Ca2+, Mg2+, Mn2+, and Co2+ increases the activity whereas K+, Fe2+, Zn2+, and Cu2+ reduces the activity. Significant inhibitory activity was observed with Hg2+ [11]. The study was aimed to determine the specificity of isolated alpha-amylase using a wide variety of substrate, pH, incubation temperature, and metal ions to find out either there was any difference or not by giving a crucial comparison between each of the parameter of the standard assay.
2. MATERIALS AND METHODS
2.1. Isolation of Microorganisms
Waste water sample was collected from agro-industrial area of Purba Bardhaman, West Bengal, India. The experimental area lies at latitude and longitude of 23°15’15.3”N and 88°01’50.9”E, respectively. A sterile container was being used to collect the water sample that was then maintained at 4°C for subsequent analysis. The essential and auxiliary screening of amylolytic fungus isolates was performed on starch agar media. Serial dilution was used to isolate the fungus. After being inoculated, Petri plates were kept at 28°C for 3–4 days. According to morphological characteristics, fungal isolates were identified. To obtain pure culture, the isolates were picked up and inoculated on sterile agar plates and incubated at 28°C for 48 h.
2.2. Screening and Selection of Potential Isolates
Starch agar plate technique with minor modifications was used to screen the Aspergillus isolates for amylase production [12-14]. The isolates with the widest clear zone were further chosen as a single strain variant.
2.3. Staining of the Pure Isolate
Microscopic morphology of the pure isolate mount was conducted employing Shamly et al.’s method [15], and territorial parameters such as size, surface appearance, texture, reverse, and coloration of the colonies were employed to view the isolate microscopically.
2.4. Extraction of Enzyme
Mineral broth medium (Starch: 5 g/L, yeast extract: 5g/L, (NH4)2SO4: 2.5g/L, MgSO4: 2 mg/L, KH2PO4: 3 g/L, CaCl2: 2.5 mg/L) was prepared. 100 mL of the medium was put into 250 mL Erlenmeyer flasks and disinfected at 121°C for 15 min. Inoculum was deposited into the flask and incubated for 96 h at 37°C with a 150 rpm rotary shaker. Finally, the fermented culture was transferred into centrifuge tubes and agitated for 20 min at 5000 rpm at 4°C before being decanted.
2.5. Determination of Enzyme Activity
Activity of alpha-amylase was determined by 3,5 Di-nitro salicylic acid (DNSA) method using potato starch as substrate and sodium phosphate buffer (pH-6.9) as the incubation medium at 37°C of incubation temperature. All the parameters were the same as the normal assay protocol [16]. Quantitative estimation of enzyme protein was determined by Lowry et al. [17].
2.6. Characterization of the Isolated Enzyme with Varying Parameters
2.6.1. Employing different substrates
Enzyme assay was carried out following the DNSA method to estimate the amount of reducing sugars given off by a different variety of conventional and unconventional Starch of plant origin at the concentration of 2.5 mg/ml, 5 mg/ml and 10 mg/ml. Different types [Table 1] and concentration of starch were taken to find out whether, with increased concentration of starch, any significant changes in the specific activity of the enzyme observed.
2.6.2. At different pH of incubation
The effect of various range of pH on alpha-amylase activity was investigated usinga sodium-phosphate buffer of pH ranges 5.7, 6.5, 6.9, 7.5 and 8.0 to find out the optimum pH through DNSA methodology [16] without changing other parameters such as substrate and incubation temperature.
![]() | Table 1: Different types of conventional and unconventional starch [Click here to view] |
2.6.3. Activity optimization at different temperatures
The influence of a wide variety of incubation temperatures on alpha-amylase activity was examined. Incubation temperature of 15°C, 25°C, 37°C, 45°C, and 55°C were used to find out the optimum temperature of incubation [16].
2.6.4. Effects of metal ions on enzyme activity
In general, Na+ is used as a standard metal ion in DNSA protocol [16]. The optimum activity of alpha-amylase in terms of ion specificity was evaluated using different metal ions such as Ca2+, Mg2+, and Zn2+ in the place of Na+ to find out whether the metal ions used in this study have any better specificity towards enzyme activity.
3. RESULTS AND DISCUSSION
3.1. Isolation of microorganisms
Based on colony morphology and microscopic mount of the isolates, seven fungal isolates were obtained in the first phase of screening. From seven fungal isolates, three fungal isolates with considerably increased clear zone generation by starch hydrolysis were chosen and further investigated [Figure 1].
3.2. Screening and Selection of Potential Isolates
Two potential isolates [Figure 2] were chosen for further characterization in the second round of screening, and the isolates were confirmed to be from the Aspergillus genus. As a result, the fungal isolate’s maximum clear zone development on starch agar media, as shown in Figure 2, revealed that the isolate is an alpha-amylase producer.
3.3. Staining of the Pure Isolate
After detailed analysis, the strain responsible for the activity was found to be Aspergillus oryzae [Figure 3].
3.4. Extraction of Enzyme
Alpha-amylase was extracted from the fermented mineral broth through centrifugation under controlled temperature and enzyme activity was determined by DNS Assay.
3.5. Determination of Enzyme Activity
Using potato starch as a substrate, the isolated enzyme exhibited a specific activity of 34.02 IU/mg of protein.
3.6. Characterization of Enzyme Activity with Varying Parameters
3.6.1. Employing different substrates
Specific activity of alpha-amylase with varying concentration of different substrate represented in Figure 4. Among all starch variety, potato starch with a concentration of 5 mg/ml showed maximum activity of 34.02 IU/mg of protein [Figure 5]. The starch granules were relatively rigid, and the enzyme activity was dependent on several factors such as crystalline structure, presences of pores and granular size, therefore the isolated enzyme showed more specific activity towards conventional starch rather than unconventional starch [18]. Using potato starch as a substrate, the isolated amylase from fungal source showed maximum specific activity depending on the substrate specificity, temperature, pH etc. The enzyme was highly substrate specific and was able to hydrolyze all types of Starch achieving highest activity at the concentration of 5 mg/ml. This can be explained by the basic theories of enzyme activity that postulate - when the substrate concentration is high, all the enzyme remains as enzyme-substrate complex, that is, the entire enzyme in the media, gets saturated by the substrate. As a consequence, as the concentration of the substrate rises, the enzyme activity increases till a certain point, after that it drops. Maximum maltose production by the experimental enzyme was achieved using conventional starch compared to unconventional starch.
![]() | Figure 1: Figure 1: Zone of hydrolysis at 28°C, pH 6.5 after 4 days of incubation by promising isolates (b-f) and absence of hydrolysis zone formation (a) [Click here to view] |
![]() | Figure 2: Plate indicating zone of hydrolysis (clear zone) by fungal isolate. [Click here to view] |
![]() | Figure 3: Colony morphology on Starch agar and microscopic mount of the potential isolate. [Click here to view] |
3.6.2. At different pH of incubation
The optimum pH of the experimental enzyme was represented in Figure 6. The enzyme is active at pH levels ranging from 5.7 to 8.0, with pH 8.0 providing the best results. Similar studies with alpha-amylase from Aspergillus sp. MK07 showed optimal activity in the pH 6.0 [19]. The enzyme was active over a range of pH 5.7–8.0 with optimum activity at pH 8.0. It might be due to the fact that fungus of Aspergillus sp. always remains active over a wide range of pHi.e.1.4–9.8 therefore; due to its presence over a wide range of pH it could be able to produce enzymes with activity over a wide range of pH [20].
3.6.3. Activity optimization at different temperatures
The optimum temperature of the experimental enzyme graphically presented in Figure 7. The isolated enzyme was found to show maximum activity at 37°C. Earlier studies also supported this observation that amylase from A. oryzae origin showed best activity between 30°C and 60°C with optimum activity at 50°C [21]. As most of the enzymes were protein in nature, so thermo-tolerance always affects the optimum activity.
3.6.4. Effects of metal ions on enzyme activity
Enzymes can get activated with the help of inorganic metal ions that aid in the catalysis of a reaction. Metals often facilitate this catalytic process either by attaching with the target enzyme during the reaction (cofactor) or permanently attached from the beginning with the enzyme (metalloenzymes). In this study, Na+ ions as a standard showed maximum relative activity toward enzyme action followed by Mg2+, Ca2+whereas Zn2+ ions showed reduced relative activity toward enzyme action [Table 2]. In the presence of ions such as Ca2+ and Mg2+, the isolated enzyme’s catalytic efficiency was reported to be decreased. According to previous experimental work Metal ions such as Ca2+, Mg2+, Mn2+, and Co2+ boost catalytic activity, whereas K+, Fe2+, Zn2+, and Cu2+ decrease it [11]. Metals can either aid in the catalytic reaction, activate the enzyme to start it, or block it. Some amylases are metalloenzymes, indicating they contain a metal ion to facilitate the process. It’s possible that the suppression is due to competition between the exogenous cation and the protein-associated cation, resulting in lower metalloenzyme activity [22].
![]() | Table 2: Effect of metal ions on enzyme activity. [Click here to view] |
![]() | Figure 4: Specific Activity of α-amylase with different concentration starch. [Click here to view] |
![]() | Figure 5: Comparison between conventional and unconventional starch. [Click here to view] |
![]() | Figure 6: Effect of pH on enzyme activity. [Click here to view] |
![]() | Figure 7: Effect of temperature on enzyme activity. [Click here to view] |
4. CONCLUSION
According to the observations, the enzyme’s activity increases up till a certain concentration (2.5 mg/ml), and after that it declines, this might be due to composition and orientation of amylose and amylopectin arrangement in the starch molecule that impact substrate binding capacity of the enzyme which gets reflected in its activity. In contrast to other forms of starch, potato starch with a concentration of 5 mg/ml was found to be more enzyme-specific as a substrate (34.02 IU/mg of protein). The enzyme was best active at pH 8.0 and with incubation temperature of 37°C using Na2+ as cofactor. The optimum temperature and pH of enzyme’s activity might also depend on the newly isolated microbial strain and its adaption to the environment.
5. AUTHORS’ CONTRIBUTIONS
All authors made substantial contributions to conception and design, acquisition of data, or analysis and interpretation of data; took part in drafting the article or revising it critically for important intellectual content; agreed to submit to the current journal; gave final approval of the version to be published; and agreed to be accountable for all aspects of the work. All the authors are eligible to be an author as per the International Committee of Medical Journal Editors (ICMJE) requirements/guidelines.
6. FUNDING
This research was partly supported by the University Research Fellowship granted by University of Calcutta.
7. CONFLICTS OF INTEREST
The authors report no financial or any other conflicts of interest in this work.
8. ETHICAL APPROVALS
This study does not involve experiments on animals or human subjects.
9. DATA AVAILABILITY
All Set of DATA analyzed in the study are openly available.
10. PUBLISHER’S NOTE
This journal remains neutral with regard to jurisdictional claims in published institutional affiliation.
REFERENCES
1. Hasan MM, Marzan LW, Hosna A, Hakim A, Azad KA. Optimization of some fermentation conditions for the production of extracellular amylases by using Chryseobacterium and Bacillus isolates from organic kitchen wastes. J Genet Eng Biotechnol 2017;1:59-68. CrossRef
2. Alrumman SA, Mostafa YS, Saleh AE, Saad AA, Hesham AE. Isolation of thermophilic α-amylase producing bacteria and optimization of potato waste water medium for enhancement of α-amylase production. Adv Life Sci Technol 2014;20:41-51.
3. Tiwari SP, Srivastava R, Singh CS, Shukla K, Singh RK, Singh P, et al. Amylases: An overview with special reference to alpha amylase. J Glob Biosci 2015;4:1886-901.
4. Sethi BK, Jana A, Nanda PK, DasMohapatra PK, Sahoo SL, Patra JK. Production of α-Amylase by Aspergillus terreus NCFT 4269.10 using pearl millet and its structural characterization. Frontin Plant Sci 2016;7:639. CrossRef
5. Naidu MA, Saranraj P. Bacterial amylase: A review. Int J Pharm Biological Arch 2013;4:274-87.
6. Parmar D, Pandey A. Characterization of amylase producing bacterial isolates. Bull Environ Pharmacol Life Sci 2012;1:42-7.
7. Sinha C. Isolation, Characterization and Optimization of Amylase Producing Bacteria from Municipal Waste, Doctoral Thesis. Kolkata, India: Jadavpur University; 2010.
8. Karri S, Talla SG, Dholpuri R, Dholpuri S. Screening, production and optimization of alpha amylase from Aspergillus strains by using solid state fermentation. Int J Curr Microbiol Appl Sci 2014;3:623-31.
9. Pandey A. Improvement in solid state fermentation for glucoamylase production. Biol Wastes 1990;34:11-9. CrossRef
10. Zahra RR, Qader SA, Pervez S, Aman A. Influence of different metals on the activation and inhibition of alpha amylase from thermophillic Bacillus firmus KIBGE-IB28. Pak J Pharm Sci 2016;29:1275-8.
11. Lee YS, Park DJ, Choi YL. Characterization of maltotriose production by hydrolyzing of soluble Starch with alpha amylase from Microbulbifer thermotolerants DAU221. Appl Microbiol Biotechnol 2015;99:3901-11. CrossRef
12. Fogarty MW. Microbial amylases. In: Fogarty WM, editor. Microbial Enzymes and Biotechnology. London, UK: Applied Science Publishers Ltd.; 1983. p. 1-92.
13. Abe J, Makajoma K, Nagano H, Hijkeri S. Production of the raw starch digesting amylase of Aspergillus sp. K-27 Synergetic action of glucoamylase and-amylase. Carbohydr Res 1988;75:85-92. CrossRef
14. Akpan I, Bankole MO, Adesemowo AM, Lantunde-Data GO. Production of alpha amylase by Aspergillus niger in a cheap solid medium using rice bran and agricultural material. Trop Sci 1999;39:77-9.
15. Shamly V, Kali A, Srirangaraj S, Umadevi S. Comparison of microscopic morphology of fungi using lactophenol cotton blue (LPCB), Iodine glycerol and congo red formaldehyde staining. J Clin Diagn Res 2014;8:DL01-2.
16. Miller G. Use of dinitrosalicylic acid reagent for determination of reducing sugar. Anal Chem 1959;31:426-8. CrossRef
17. Lowry OH, Rosenbrough NJ, Farr AL, Randall RJ. Protein measurement with the folin phenol reagent. J Biol Chem 1951;193:265-75. CrossRef
18. Kaur LD, Singh J. Advances in Potato Chemistry and Technology. Amsterdam, Netherlands: Elsevier; 2009.
19. Chimata MK, Chetty CS, Suresh C. Fermentative production and thermostability characterization of α-amylase from Aspergillus species and its application potential evaluation in desizing of cotton cloth. Biotechnol Res Int 2011;2011:323891. CrossRef
20. Schuster E, Dunn-Coleman N, Frisvad J, van Dijck P. On the safety of Aspergillus niger-a review. Appl Microbiol Biotechnol 2002;59:426-35. CrossRef
21. Shah IJ, Gami PN, Shukla RM and Acharya DK. Optimization for α-amylase production by Aspergillus oryzae using submerged fermentation technology. Basic Res J Microbiol 2014;1:1-10.
22. Lévêque E, Janecek S, Haye B, Belarbi A. Thermophilic archaeal amylolytic enzymes. Enzyme Microb Technol 2000;26:3-14. CrossRef